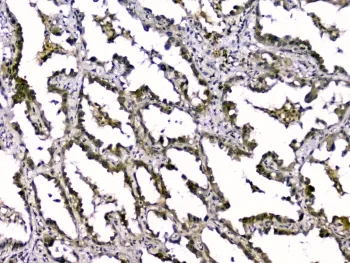
TGFB2 Antibody / TGF beta 2 - image 1

TGFB2 Antibody / TGF beta 2
CAT:
800-RQ4448
Size:
100 µg
Price:
Ask
- Availability: 24/48H Stock Items & 2 to 6 Weeks non Stock Items.
- Dry Ice Shipment: No

TGFB2 Antibody / TGF beta 2
Description:
This gene encodes a secreted ligand of the TGF-beta (transforming growth factor-beta) superfamily of proteins. Ligands of this family bind various TGF-beta receptors leading to recruitment and activation of SMAD family transcription factors that regulate gene expression. The encoded preproprotein is proteolytically processed to generate a latency-associated peptide (LAP) and a mature peptide, and is found in either a latent form composed of a mature peptide homodimer, a LAP homodimer, and a latent TGF-beta binding protein, or in an active form consisting solely of the mature peptide homodimer. The mature peptide may also form heterodimers with other TGF-beta family members. Disruption of the TGF-beta/SMAD pathway has been implicated in a variety of human cancers. A chromosomal translocation that includes this gene is associated with Peters' anomaly, a congenital defect of the anterior chamber of the eye. Mutations in this gene may be associated with Loeys-Dietz syndrome. This gene encodes multiple isoforms that may undergo similar proteolytic processing.UniProt:
P61812Host:
RabbitImmunogen:
Amino acids ALDAAYCFRNVQDNCCLRPLYIDFKRDLGWKWIHEPK were used as the immunogen for the TGFB2 antibody.Clonality:
PolyclonalIsotype:
IgGApplications:
WB, IHC-PFormat:
Antigen affinity purifiedBuffer:
0.5mg/ml if reconstituted with 0.2ml sterile DI waterReconstitution:
After reconstitution, the TGFB2 antibody can be stored for up to one month at 4oC. For long-term, aliquot and store at -20oC. Avoid repeated freezing and thawing.Limitations:
This TGFB2 antibody is available for research use only.CAS Number:
9007-83-4